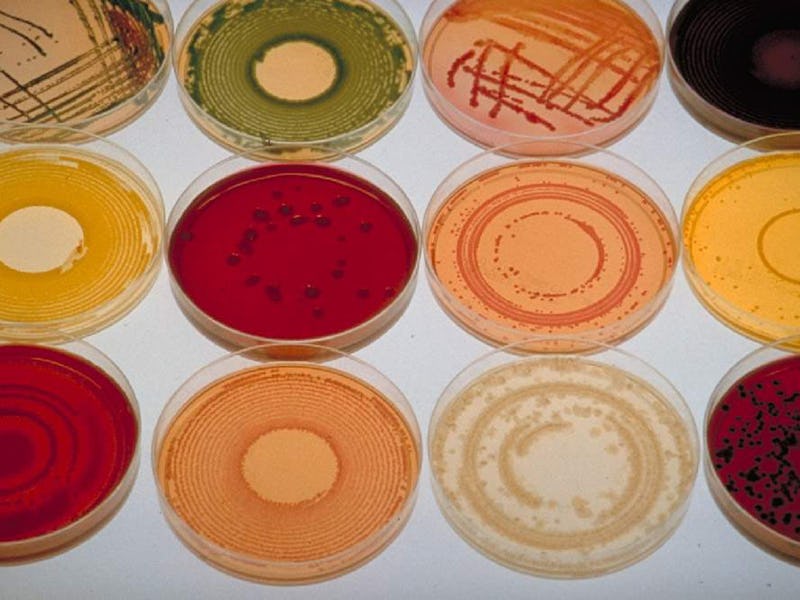

Everything You Need to Know About Obama's New Microbiome Initiative
Tiny organisms. Big budgets.
The White House Office of Science and Technology Policy recently announced a comprehensive, big-budget collaborative study of microbiomes called the National Microbiome Initiative (NMI). The NMI has three primary goals: supporting interdisciplinary research, developing platform technologies, and expanding the microbiome workforce.
You might not know what a microbiome is, but you’re probably familiar with the concept of microorganisms. A microbiome is simply the term for a community of microorganisms, which could be in the ocean, in the ground, in the atmosphere, or even on people.
According to the White House, the federal government will pour more than $121 million into the initiative in the coming year. The money will come from the Department of Energy, NASA, the National Institute of Health, the National Science Foundation, and the U.S. Department of Agriculture. The Bill and Melinda Gates Foundation also threw in a cool $100 million, to be dispensed over the course of the next four years. Here are seven of the biggest takeaways:
1. Microbiologists have been hoping for this for a while
In October 2015, more than a dozen leading microbiologists published an article in Science calling for a Unified Microbiome Initiative. “What we’re trying to do is to coordinate ourselves in the same way that the physics community did several decades ago — think of lots of mini-CERNs,” Dr. Jack Gilbert, one of the authors and a professor in the Department of Ecology & Evolution at the University of Chicago told the Atlantic. “We won’t just have one agency releasing a call for proposals and all of us scrambling to get a piece of the pie. We’re not going to have as many parallel reinventions of the wheel.” Gilbert and his colleagues are certainly getting the opportunity to coordinate now.
2. That Gates Foundation money will go toward studying nutrition and crop protection
The Gates Foundation’s $100 million is the NMI’s single largest investment. According to the White House, the funds will go toward clinical studies on the effect the human microbiome has on childhood malnutrition and trials that will attempt to control or reverse the damage caused by that malnutrition. The money will also support the health of crops in Sub-Saharan Africa. The Gates Foundation is known especially for its work in controlling disease and malnutrition in the developing world.
3. Ann Romney is involved
The Ann Romney Center for Neurological Disease at Brigham and Women’s Hospital plans to establish a Microbiota-Gut-Brain Center of Excellence, which will study how microbiomes relate to many of today’s big-name diseases, including multiple sclerosis and Alzheimer’s.
4. So is the Mayo Clinic
The Mayo Clinic Center for Individualized Medicine plans to launch a $1.4 million Microbiome Clinic. The clinic will focus both on conducting clinical trials and educating patients about microbacterial health.
5. The University of Chicago is building The Microbiome Center
The university is pouring in $1.3 million to host a “research community” in the new center. Its partners in the venture are the Marine Biological Laboratory (MBL) and the U.S. Department of Energy’s Argonne National Laboratory.
6. Bio-tech company C3 Jian is putting in $75 million
C3J’s rather generous investment will help “develop and commercialize safe and effective pathogen-specific antimicrobials that correct microbial imbalances in many human diseases.” C3J’s work will also focus on fighting childhood tooth decay and cavities.
7. Also just created? The Microbiome Coalition (TMBC)
Seven scientific research institutions — AO Biome, Abbott Nutrition, CosmosID, Diversigen, the Mayo Clinic, Second Genome, and Whole Biome — will collaborate on the following goals: “promote greater public understanding of the role of the microbiome in human health and wellness; advance microbiome education, investment and infrastructure; and facilitate collaborative discussions and relationships among the companies, academic laboratories, and government funding, regulatory, and scientific agencies that will play a key role in translating findings in microbiome research to applications in diagnostics, therapeutics, adjunct therapies, and direct-to-consumer products.”